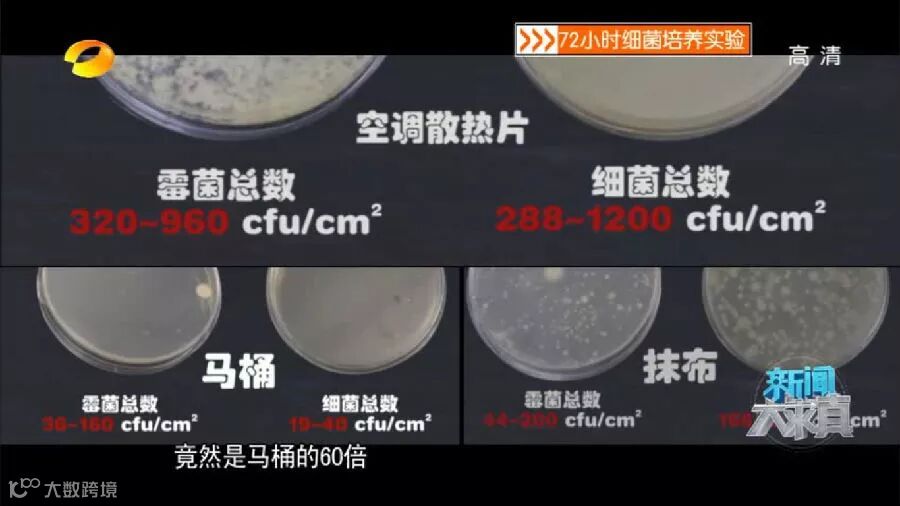

高温天到来,一开空调,一股异味,你还敢继续吹么?

前几天,杭州的高温天说来就来,短短几天,公司便收到若干个咨询电话:效果不好?一开机一股异味?公司迅速组织人员上门,查看后发现:大部分原因是开机前没有进行空调清洗。

不止是家庭,很多商场、宾馆、写字楼等公共场所,卫生部曾多次抽检发现,同样存在装了中央空调以后,就从来没有清洗过。



看着是否触目惊心?







1
为什么要对中央空调进行清洗?
01 长期未清洗的空调比马桶还脏
空调污染是夏季室内空气污染的主要因素,而空调散热片是空调污染的罪魁祸首。
复旦大学公共卫生学院的专家检测了30户居民使用的分体壁挂式空调散热片和马桶内壁,结果发现,空调散热片的细菌含量是马桶的60余倍,而霉菌的总数是马桶的近30倍。

可怕的“杀手”名单
研究发现,常年不洗的空调中,存在大量致病菌或者微生物,比如白色念珠菌等霉菌、蜡样芽孢杆菌、金黄色葡萄球菌、大肠杆菌等细菌及螨虫等。


经中国环境科学学会调查检测表明:不洁的空调送出来的螨虫至少有上万只之多!
“空调病”的来源
长时间不清洗空调,过滤网上吸附着大量的灰尘、螨虫、花粉、霉菌,当空调一开,这些病菌、灰尘就被空调吹出来,可以引发大规模的感染,通常表现为鼻塞、头昏、打喷嚏、喉咙干、耳鸣、眼睛刺痛、皮肤过敏等症状,这些症状被我们统称为“空调病”。

“空调病”看起来似乎是室内外温差过大造成的,但真正的致病原其实就是在空调里的细菌,也包括PM2.5。

2
中央空调清洗有什么好处?
01 减少故障,延长使用寿命
按照国际惯例,中央空调每年都必须科学清洗保养一次,否则就会出现生物粘泥堵塞,而污垢很重时,压缩机磨损大大加大,缩短压缩机使用寿命,甚至烧毁马达,增加维修费用。通过清洗,散热片能回到洁净状态,温度回到正常,压缩机得到良好润滑,减少空调机组故障。
彻底清净空调器污染源,避免引起并传播疾病,过滤污浊空气,去除烟味、汗味、体味。保持室内空气清新、解除因空气质量问题而产生的头晕、因倦、打喷嚏,减少空调病等。
彻底清洗空调室外机能节约大量电费。空调在无数次的重复运行中,空气中夹杂的大量尘埃和液态烟雾就会层层包裹散热片,并严重堵塞散热片之间微小空隙,影响散热片的散热,从而导致冷凝器压力升高,压缩机马达电流增大,运行时间成倍延长,耗电量显著增加。

3
为什么要找专业人员清洗中央空调?
中央空调清洗这么重要,那么是不是自己清洗一下就可以了呢?小编只想提醒大家,如果只清洗过滤网,是远远无法解决空调污染的!
中央空调清洗包括三大块:基础清洗、换季清洗以及深度清洗。像基础清洗保养是可以自己来的,但是像一些专业的深度清洗保养就必须要找专业的人员来。

中央空调专业清洗
1:对室内、室外换热器的表面进行清洗,除去灰尘和可繁殖的细菌等,这样可提高换热器的效率,防止有害物质积累。
2:对空气过滤网进行清扫和更换,空气过滤网是一种长效除臭空气滤清过滤网,它可以大大提高空调的清新空气质素,在清扫时,注意拆卸过程中不要碰到室内机组的金属部分,因为很容易对其造成损伤。
3:对排水部分的清洁,因为排水部分累积的污垢比较多,需要对其进行彻底的清扫和消毒,确保排水的畅通。
4:进行深度清洁,对中央空调的电路控制部分进行灰尘的清除,检查各接触件,确保电路控制部分的安全稳定运行;然后对主机的工作指标进行检查,对主机运转存在的隐患进行排除,对一些松动的部件进行及时的处理等。

使用超过一年的空调应进行深度清洗。因为深度清洗需要拆开空调进行,并需要使用专门的药水和工具进行清洗。而非专业人员容易损坏电路板,从而导致漏电或短路,甚至引发火灾,应由专业人士进行。
华盟深度清洗专业工具



华盟专业清洗团队




华盟空调清洗服务,能够专业清洗各种类型、各种品牌的中央空调,无论是水系统中央空调还是氟系统中央空调,本着用心服务的服务准则,为顾客在即将来临的炎炎夏日送去凉爽。
喜迎6.18年中大促,即日起至7月18日,预约中央空调清洗享9折优惠,将本文转发朋友圈,集满30个赞,即可再抵空调清洗费用100元!
(注:朋友圈集赞活动,需要现场截图方可抵用)

华盟环境——打造杭城最专业的中央空调设计、安装、 售后服务商。
清洗热线:0571-88162656
网址:www.51hkt.com
地址:杭州市西湖区西溪湿地北门西溪壹号24号楼一楼

